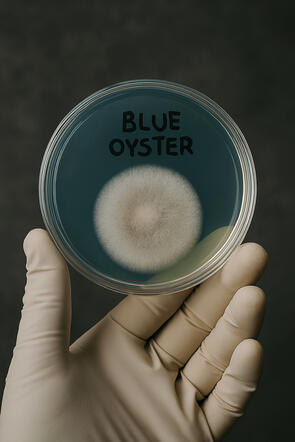
Untitled Untitled

MycoBardsley produces gourmet mushrooms with a focus on commercial consistency and lab-grade precision. Working from a controlled, documented environment in Lancashire, we grow Blue Oyster and other culinary varieties using clean, repeatable methods that ensure reliable yields and premium quality. Our workflow supports both fresh mushroom production and additional offerings such as sterilised substrate and commercial-grade cultures for growers and community projects.

Our ProductsFresh Gourmet Mushrooms
We specialise in Blue Oyster and other culinary varieties grown with clean, controlled methods that ensure consistent quality and reliable yields. Ideal for home cooks, local markets, and small‑scale wholesale supply.Sterilised Straw Substrate
Prepared in‑house using documented, repeatable processes for contamination‑resistant performance. Suitable for growers who want dependable results without the prep work.Commercial‑Grade Cultures
Our Blue Oyster cultures are maintained in a controlled lab environment and supplied ready for expansion. Perfect for growers, community projects, and educational programmes.

Our Lab ProcessSterile Workflow
Our lab operates under clean, documented protocols using a still air box (SAB) and sterilised tools. Every step is designed to minimise contamination and ensure repeatable results.Culture Maintenance
We maintain Blue Oyster cultures on agar plates and grain spawn under controlled conditions. Cultures are tracked and rotated to preserve vigour and consistency.Substrate Preparation
Straw substrate is pasteurised and sterilised in-house using a retort kiln fabricated by CDMS Solutions. Each batch is labelled, logged, and sealed for traceability.Inoculation & Incubation
Inoculation is performed in sterile conditions, followed by incubation in a temperature‑controlled environment. Growth stages are monitored and documented to ensure optimal colonisation.
Have a question about our products, processes, or availability?
We’re always happy to help. Reach out and we’ll get back to you as soon as possible.